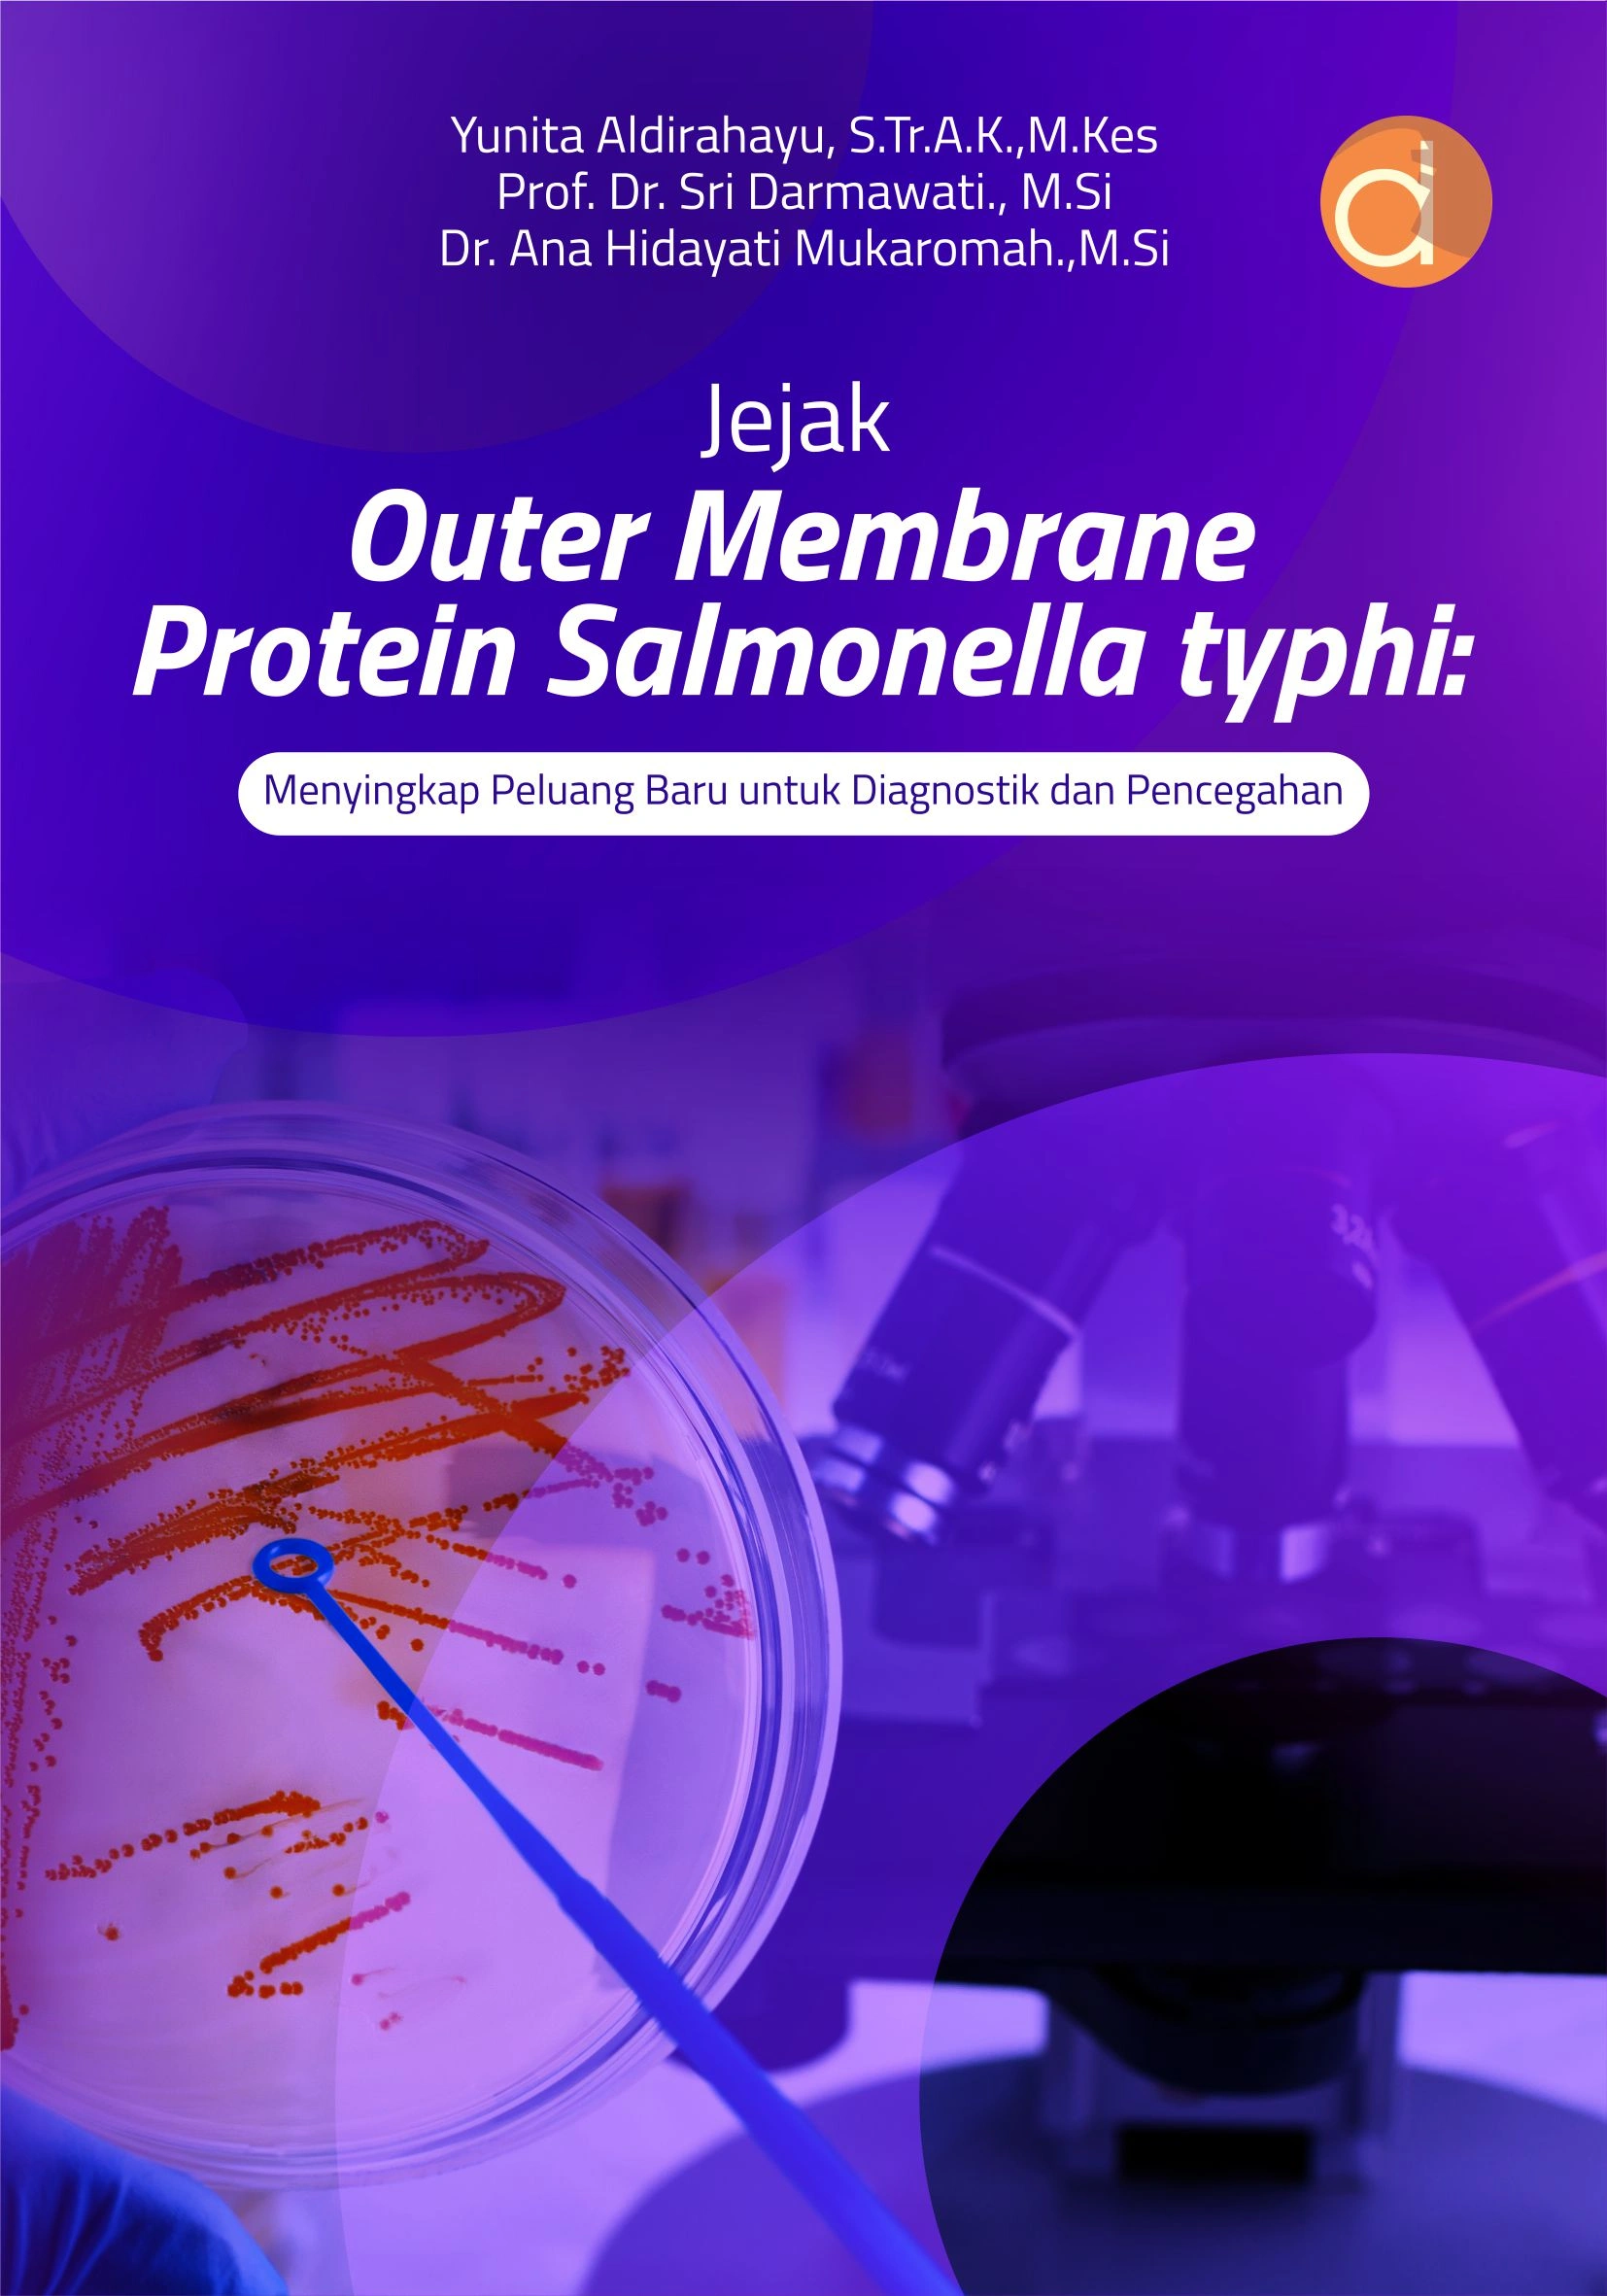

Deskripsi
Sinopsis Buku Jejak Outer Membrane Protein Salmonella typhi: Menyingkap Peluang Baru untuk Diagnostik dan Pencegahan
Buku Jejak Outer Membrane Protein Salmonella typhi: Menyingkap Peluang Baru untuk Diagnostik dan Pencegahan
Buku Kesehatan yang berjudul Buku Jejak Outer Membrane Protein Salmonella typhi: Menyingkap Peluang Baru untuk Diagnostik dan Pencegahan merupakan karya Yunita Aldirahayu, Sri Darmawati dan Ana Hidayati Mukaromah. Demam tifoid, yang disebabkan oleh bakteri Salmonella typhi, masih menjadi ancaman kesehatan endemik yang serius di Indonesia, diperburuk oleh sanitasi yang terbatas dan meningkatnya resistensi terhadap antibiotik modern. Lalu, bagaimana kita dapat mendeteksi dan mengendalikan infeksi ini secara lebih akurat?
Jawabannya tersembunyi dalam dunia molekuler bakteri itu sendiri. Buku ini mengajak Anda menelusuri Outer Membrane Protein (OMP) S. typhi—protein kunci yang bertanggung jawab memicu respons imun dan menjadi kandidat utama untuk pengembangan alat diagnostik yang lebih spesifik. Penulis mengupas tuntas profil unik protein ini, potensinya dalam mendeteksi penyakit, dan implikasinya terhadap strategi pencegahan. Disajikan secara komprehensif namun mudah dipahami, Buku Jejak Outer Membrane Protein Salmonella typhi: Menyingkap Peluang Baru untuk Diagnostik dan Pencegahan ini adalah panduan esensial bagi mahasiswa biologi/kedokteran, tenaga kesehatan, dan masyarakat yang ingin memahami akar biologis demam tifoid. Kenali musuh Anda dari tingkat molekuler untuk menghadapi tantangan kesehatan masyarakat secara lebih efektif.
Berikut Daftar Isi Buku Kesehatan yang berjudul Buku Jejak Outer Membrane Protein Salmonella typhi: Menyingkap Peluang Baru untuk Diagnostik dan Pencegahan, diantaranya:
- Mengenal Lebih Dekat S. typhi dan Perannya dalam Deteksi Demam Tifoid
- Mengurai Kompleksitas Biologi dan Patogenitas S. typhi di Era Diagnostik Modern
- Peran Imunogenik OMP pada Salmonella typhi
- Diagnosis Demam Tifoid dan Protein OMP
- Peran OMP S. typhi dalam Pengembangan Antigen dan Deteksi Demam Tifoid
- Menelusuri Imunogenesitas OMP S. typhi Melalui Isolasi dan Karakterisasi Molekuler
- Jejak Molekuler OMP S. typhi dalam Pemahaman Biomarker dan Imunogenesitas
Spesifikasi Buku
Kategori Buku: Buku Kesehatan
Penulis : Yunita Aldirahayu, Sri Darmawati, Ana Hidayati Mukaromah
Editor : Farisa Iffa Tiara Dewi
Halaman : xiv, 158 hlm., Uk.: 14×20 cm
ISBN : 978-634-01-1930-5
Tahun Terbit : 2025
Buku Jejak Outer Membrane Protein Salmonella typhi: Menyingkap Peluang Baru untuk Diagnostik dan Pencegahan diterbitkan oleh Penerbit Buku Pendidikan Deepublish.
Dapatkan buku-buku berkualitas hanya di Toko Buku Online Deepublish. Kami berfokus menjual buku-buku kuliah untuk Mahasiswa di seluruh Indonesia, dengan pilihan terlengkap kamu pasti mendapatkan buku yang Anda cari.
Kelebihan kami :
- Buku Baru
- Original
- Pengiriman Cepat
- Stok selalu tersedia
- Packing aman & rapi
- Garansi 100% jika produk rusak/cacat/tidak sesuai KAMI GANTI atau UANG ANDA KEMBALI
Rekomendasi Buku Lainnya
Buku Ekonomi | Buku Akuntansi | Buku Bahasa Inggris | Buku Hukum | Buku Novel

Review
Belum ada ulasan.